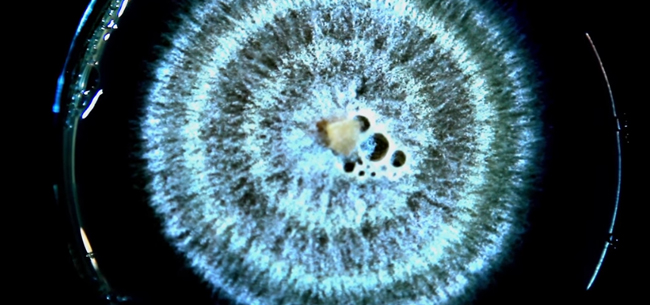
6757576

Грибы съедобные и плесень. Выращивание грибов в искусственных условиях. Роль грибов и плесени в жизни человека.
Грибы-паразиты, грибы-хищники, споры, ядовитая плесень… До недавнего времени грибы относили к растениям, но, когда ученым стал доступен генетический анализ, стало совершенно очевидно, что у грибов гораздо больше общего с животными. Например, грибы вырабатывают хитин, что свойственно насекомым.
В фильме рассказывается о двух основных видах грибов: грибы съедобные и плесень. Процесс выращивания грибов в искусственных условиях. Роль плесени в жизни человека.
Изучая грибы, ученые находят лекарства от болезней, создают новые продукты питания и раскрывают тайны жизни.
http://www.naukatv.ru



Ваш комментарий будет первым